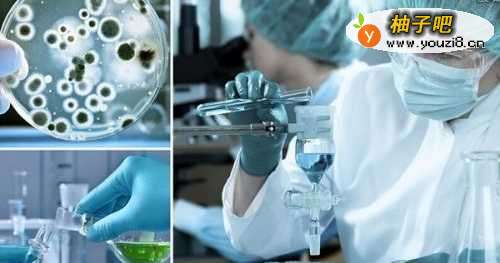

如何提高新药的生物利用度
整理:皮耶罗德曼
时间:2025-11-01
阅读:29

随着科学技术的发展,随着社会的进步,越来越多的事情变得方便、高效和有价值,其中也包括医药行业。生物科技研究有很大的突破,一些研究机构也研发出了一些新药,作为医药行业的从业者,该如何提高新药的生物利用度呢?
操作方法
1 2
2 3
3 4
4 5
5 6
6
提高新药的生物利用度需要:选对合适的试验对象。要提高新药的生物利用度,就需要先做临床试验,所以第一步就是要选对合适的试验对象,让自己的新药的功能能够完全展现出来。
 2
2提高新药的生物利用度需要:结合其他的试剂等东西一起来提高新药的药效。其实要提高新药的生物利用度就是为了解决病人的痛苦,解除疾病对人的伤害,而有些新药需要配合其他的药剂等才会起到更大的作用。
 3
3提高新药的生物利用度需要:合理的比例,也就是新药的剂量要设计清楚,不要过多,也不能太少。要提高新药的生物利用度,就需要把握好这个度,选择合适合理的比例,才能让自己的新药起到效果。
4
4提高新药的生物利用度需要:找专业的医院来合作,一起提高新药的生物利用度。根据新药的疗效来选择合适的医院,也可以提高新药的生物利用度,比如垂直型的医院,儿童医院、眼科医院等等。
 5
5提高新药的生物利用度需要:选择合适的医生来操作。专业的事情要由专业的人来完成,提高新药的生物利用度也不例外,需要找到合适的医生,具备一定的专业知识,有丰富的经验。
 6
6提高新药的生物利用度需要:进行新药产品发布会、推广会等等。经过严格的临床试验之后,证明这款新药适合市场,符合相关要求。那么要提高新药的生物利用度就需要进行一系列的宣传工作。

同类经验分享
- 谷歌拼音输入法怎么敲出特殊符号11-26
- 狗狗耳朵清洁护理有什么方法?11-26
- 钉钉如何设置允许非好友查看我的企业认证信息?11-19
- 如何更好地处理婆媳矛盾11-19
- 萌妆的打造方法11-19
- 家具设计之客厅电视柜家具手绘举例11-17
- 汽车美容知识全攻略11-26
- 怎么做美人鱼手工制作11-26
- 小孩很不听话怎么办?11-17
- 微信6.6怎么关闭搜一搜07-27
站内热点
- 谷歌拼音输入法怎么敲出特殊符号11-26
- 狗狗耳朵清洁护理有什么方法?11-26
- 钉钉如何设置允许非好友查看我的企业认证信息?11-19
- 如何更好地处理婆媳矛盾11-19
- 萌妆的打造方法11-19
- 家具设计之客厅电视柜家具手绘举例11-17
- 汽车美容知识全攻略11-26
- 怎么做美人鱼手工制作11-26
- 小孩很不听话怎么办?11-17
- 微信6.6怎么关闭搜一搜07-27
近期更新
- 家常实惠藕饼的做法11-01
- 吃哪些食物最健康比吃药还好11-01
- 豆腐和什么炒最好吃11-01
- 肉皮冻怎么做11-01
- 家中自制水煮肉片,麻辣鲜香又好吃11-01
- 父母学会这5条,孩子将受益一生11-01
- 怎样解决小孩爱哭倔的问题11-01
- 孩子总是犟嘴怎么办11-01
- 怎样处理好与父母的关系?11-01
- 西芹五花肉炒油豆腐的做法11-01
- 怎么炸小虾最酥最好吃11-01
- 感情中什么样的女人不受男人待见?11-01

